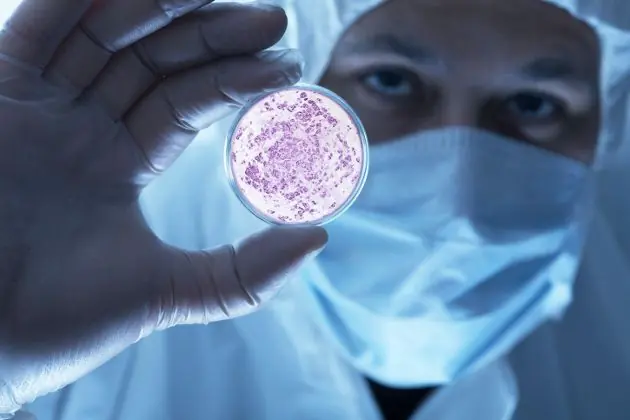
diferencias

En ocasiones, nos referimos erróneamente a virus y bacterias como si fueran lo mismo o sinónimos. Esta confusión es normal, ya que estos microorganismos tienen algunas similitudes, como por ejemplo, que ambos pueden ser causantes de enfermedades. Sin embargo, esto es un error ya que estos microorganismos tienen más diferencias que puntos en común.
A continuación los invito a conocer un poco más sobre las características y las diferencias que existen entre virus y bacterias.

Características de los virus
A grandes rasgos, podemos definir a los virus como organismos acelulares (sin células), compuestos de ácido nucleico, que no tienen metabolismo propio y para replicarse necesitan habitar en las células de otro organismo vivo, las cuales se denominan células huésped.
Los virus no respiran, no se mueven ni crecen. Sin embargo, sí se reproducen y mutan y se pueden adaptar a nuevos huéspedes.
Su tamaño es realmente muy pequeño, generalmente se encuentra entre los 20 a 300 nm. (milmillonésima parte de un metro).
Una de las enfermedades más graves e importantes causada por un virus es el HIV (virus de

Características de las bacterias
Las bacterias son microorganismos unicelulares. Su tamaño por lo general es de unos pocos micrómetros de largo y pueden adoptar diferentes formas según las cuales se las clasfica (barras curvas, esferas, barras, y espirales).
Las bacterias tienen toda la estructura celular necesaria para su crecimiento y reproducción. En general, se reproducen de forma asexuada, aunque existen casos en los que el material genético necesario para la reproducción se transmite de una bacteria a otra.
Además, las bacterias no son necesariamente nocivas para el organismo; de hecho, determinadas partes de nuestro cuerpo, como por ejemplo los intestinos, necesitan mantener un determinado equilibrio en la cantidad de bacterias para funcionar correctamente. Si esas bacterias son eliminadas, por ejemplo cuando tomamos antibióticos para otras afecciones, pueden producirse diarreas.
También hay ciertos alimentos que deben mantener una cantidad determinada de bacterias como por ejemplo el yogur y algunos quesos.
Una de las bacterias más temidas, sobre todo en el pasado, cuando se sabía menos de ella y no había tantos medicamentos, es la bacteria causante de tuberculosis, llamada mycobacterium tuberculosis o bacilo de Koch.

En qué se diferencian virus y bacterias
Al analizar detalladamente las características de virus y bacterias ha quedado claro que se trata de microorganismos diferentes, pero para que quede aún más claro vamos a analizar las diferencias que existen entre ellos.
Una de las principales diferencias radica en la forma de vida. En el caso de las bacterias está claro que se trata de un organismo vivo, ya que tienen una célula. En el caso de los virus no está tan claro, ya que no tienen células y por ende necesitan de un huésped para sobrevivir y reproducirse.
Otra de las diferencias es que las bacterias, en algunos casos como los que vimos, pueden resultar beneficiosas. En cambio, los virus no lo son (a excepción de algunos estudios que se están realizando de virus capaces de destruir tumores cerebrales).
También difieren en su tamaño, las bacterias en general son más grandes que los virus, ellas pueden llegar a medir unos 1000 nm., mientras que los virus miden entre 20 y 300 nm.

El modo de reproducción es otra de las características que diferencian a los virus de las bacterias, mientras que estas tienen en la mayoría de los casos una reproducción asexual, en el caso de los virus se invade una célula huésped, haciendo copias del ADN viral / ARN, destruyendo la célula huésped e invadiendo nuevas células que serán infectadas.
En el caso de las bacterias, la infección es localizada, mientras que en el caso de los virus se produce de forma sistémica.
La forma de combatir a virus y bacterias es diferente, mientras que para combatir una bacteria es necesario tomar o inyectar un antibiótico, para combatir los virus se utilizan antivirales y también vacunas preventivas.
Y bueno, ya que hemos hablado de sus diferencias, repasemos rápidamente sus similitudes: convivimos a diario con ellos, lo cual no quiere decir que estemos enfermos, y, aunque ambos pueden causar enfermedades, existen bacterias que son benéficas y hasta necesarias para nuestro organismo.

